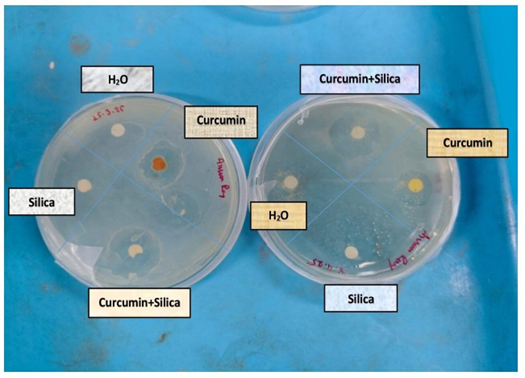

We use cookies to ensure our website works properly and to personalise your experience. Cookies policy

We use cookies to ensure our website works properly and to personalise your experience. Cookies policy
1,5 School of Materials Science and Nanotechnology, Jadavpur University, Kolkata, West Bengal, India
2 Baruipur College, University of Calcutta, South 24 Parganas, West Bengal, India
3Senior Consultant Microbiologist, Peerless Hospital and B.K Roy Research Centre, Kolkata, West Bengal, India
4 Institute of Engineering and Management, Kolkata ,West Bengal, India
Curcumin, the bioactive compound with strong antibacterial properties presents in turmeric faces challenges in clinical applications due to its poor solubility, instability and low skin permeability. In this study we aim to develop a curcumin-loaded, silica-based transdermal patch to enhance its stability of sustained release along with antibacterial activity. Mesoporous silica nanoparticles (MSNs) are synthesized using acid and base-catalyzed sol-gel method at room temperature to optimize surface properties and drug-loading efficiency. Curcumin is incorporated into the silica matrix using sol-gel co-loading method after extraction from turmeric. Characterization techniques such as XRD, FTIR, DLS-Zeta Potential, BET are performed to know the elemental composition and binding patterns. [1] Release kinetics, including burst and sustained release, are studied in pH 7.4 and pH 5.5 media. The curcumin-loaded silica is then incorporated into a PVA/PVP/EC-based transdermal patch in three different patch formulations for comparative study and drug release is monitored over 144 hours using a Franz Diffusion Cell. Antibacterial efficacy is evaluated against Gram-positive (Staphylococcus aureus) and Gram-negative (Pseudomonas aeruginosa)using disc diffusion method. Bacterial Minimum Inhibitory Concentration (MIC) and bacterial-growth kinetics results highlight significant antibacterial activity of curcumin.[2] This study demonstrates a promising approach for transdermal antibacterial therapy, utilizing silica nanoparticles to improve curcumin’s slow and sustain release for longer period .The developed patch also provides biocompatibility and painless alternative to conventional antibiotics without any side effects. Furthermore, this herbal drug in the form of a newly synthesized patch can find its future prospects in the field of medicine (localized medication) avoiding oral administration.[3]
Curcumin, a natural polyphenolic compound derived from Curcuma longa, possesses a wide range of therapeutic applications including anti- inflammatory, antioxidant, antibacterial, etc. Despite its promising therapeutic potential, curcumin’s clinical application is limited due to its poor aqueous solubility, low bioavailability and rapid metabolic degradation. When administered orally, curcumin undergoes extensive first- pass metabolism in the liver and intestines, resulting in minimal systemic absorption. Furthermore, its bitter taste and poor stability in the gastrointestinal environment arise challenges for effective oral delivery mainly in paediatric and geriatric populations.[4]
To overcome these limitations, alternative routes of administration are explored for example the transdermal drug delivery system (TDDS)[5] that offers many advantages including sustained drug release, improved patient compliance and ease of administration. However, the transdermal delivery of curcumin is inherently difficult due to its poor solubility and inadequate skin permeability.
Recent advancements in nanotechnology have provided promising strategies to enhance the solubility and skin permeation of poorly soluble drugs like curcumin. Nanoparticle-based systems improve drug delivery by increasing the surface area and improving drug solubility and stability. Among various nanocarriers, silica nanoparticles (SNPs) have gained considerable attention in biomedical applications due to their high drug loading capacity, biocompatibility and porosity. The strong Si–O bonds in silica provide structural integrity and their large surface area allows to accommodate drugs. [6][7]
In this article, curcumin drug delivery via transdermal formulations has been proposed, considering its therapeutic potential and inherent limitations such as poor aqueous solubility and low skin permeability. Curcumin-loaded silica nanoparticles (SNPs) are incorporated into the patch formulations to enhance solubility and facilitate penetration. An ex vivo skin permeation study is conducted to comparatively evaluate the diffusion of curcumin from each formulation. The cumulative drug release profiles are analysed over time to assess the effectiveness of silica encapsulation in enhancing sustained transdermal delivery of curcumin.
MATERIAL SYNTHESIS:
Materials:
For the synthesis of silica nanoparticles, we did Sol-Gel method .[2] The chemicals used in this study included Tetraethyl orthosilicate (TEOS),Sodium chloride (NaCl), Hydro chloric acid (HCL),Ethanol all of which were purchased from Sigma-Aldrich. Polyvinyl alcohol (PVA) was obtained from HiMedia Labs and di-n-butyl phthalate was bought from Ranbaxy Laboratories. Ethylcellulose (EC) and polyvinylpyrrolidone (PVP) were purchased from Loba Chemie Pvt. Ltd. Raw turmeric roots were purchased from the Jadavpur station market. All chemicals used were of analytical reagent (A.R.) grade and deionized water was used during the sol-gel process.
Synthesis if Silica nanoparticles:
Silica nanoparticles were synthesized by acid and base-catalysed sol-gel method at room temperature (around 35-degree Celsius).[7] This method involves hydrolysis of the silica precursor, tetraethyl orthosilicate commonly known as TEOS, followed by poly-condensation of the hydrolysed products. Deionized water, ethanol and TEOS were taken in a volume ratio of 1:2:1. The mixture of deionized water and ethanol was put on magnetic stirring at 350 rpm followed by the dropwise addition of the mixture of ethanol and TEOS for around 1 h. Then, the resulting colloidal solution i.e. the sol was dried at 45 degrees Celsius for the gel formation then it was put for calcination at 400 degrees Celsius for 5 hours and ground to form white silica powder by mortar and pestle.
Table 1: Molar ratio of the precursors for acid catalysed silica (S2) & base catalysed silica (S1) sample with concentrations
|
TEOS |
Ethanol |
DI water |
Catalyst |
|
10ml |
20ml |
10ml |
HCL (2drops) |
|
10ml |
20ml |
10ml |
NH4OH(2drops) |
Extraction of Curcumin from turmeric and loading into Silica nanoparticles:
Curcumin encapsulated silica nanoparticles were prepared using the sol-gel method.[7][8] TEOS was added to ethanol-water-ammonia mixture (for base catalysed) and HCL mixture (for acid catalysed ) under continuous stirring at 250 rpm to form a silica sol. Firstly, turmeric powder was prepared by washing fresh turmeric roots, followed by boiling, drying and grinding.[8][9] The cleaned roots were first boiled to remove the raw Odor and then dried until it became completely moisture-free. Finally, the dried roots were ground into a fine powder using a mechanical grinder and stored in an airtight container for further use. This turmeric powder was then dissolved in ethanol overnight and filtered by using wattman filter paper dropwise. Afterward it was added to entrap within the forming silica network. After aging it was put on centrifugation and dried at 30-35 degree celcius. Finally, it was again ground in Morter pestle to get fine powder of curcumin loaded silica nanoparticles. Curcumin is entrapped within silica nanocarriers by weak interactions like hydrogen bonding not chemical bonds and change in pH can trigger its release

(a) Base(S1) and acid(S2) catalysed silica nanoparticles

(b) Curcumin loaded onto S2

(c) Curcumin loaded onto S1
Figure 1: Bare silica nanoparticles (S1 & S2) and curcumin encapsulated onto S1 & S2 .
PATCH PREPERATION:
We prepared a transdermal patch with curcumin and silica entrapped curcumin to observe the sustained release.
To formulate a transdermal patch with curcumin we need the following materials : Ethylcellulose (EC), polyvinyl alcohol (PVA), polyvinyl pyrrolidone (PVP), Di-n-butyl phthalate, Ethanol, curcumin extract, curcumin entrapped silica nano particles.
At first, the bottom portion of both sides opened cylindrical glass mould was wrapped with aluminium foil. After that, 5 mL of 4% (w/v) aqueous solution of polyvinyl alcohol (PVA) was poured on the foil and then the mould with PVA solution was kept for drying at 40 °C for 12 hrs in the hot air oven to obtain the backing membrane of the patch.[10][11] Second step was to prepare the matrix by mixing EC-PVP[12] (2:1) and 100 mg curcumin loaded SNPs in 10 mL ethanol and poured it on the dried PVA layer. Ten per cent (v/v) of Di-n-butyl phthalate was used as a plasticizer.[13] Thus a uniform dispersion was cast on the PVA backing membrane. Now the mould was allowed to dry again at 40? for 12 hrs. The dried patch was taken out from the mould and stored in a desiccator for further studies. Thus, patches were prepared without nanoparticles, only with curcumin and curcumin loaded silica nanoparticles (acid catalyst and base catalyst) keeping the other constituents and amount same.
Table 2: Materials used to prepare transdermal patches with their amount
|
No of Patches |
Patch formulations |
Amount of polymers |
|
1 |
Blank Patch |
4% aqueous solution of PVA |
|
2 |
Pure drug loaded patch(F3) |
EC: PVP = 2:1 Wt. ratio |
|
3 |
Base catalyzed silica loaded drug(F2) |
10% (v/v) Di-n-butyl phthalate |
|
4 |
Acid catalyzed silica loaded drug(F1) |
|

Figure 2: Patch with Curcumin loaded S2

Figure 3: Patch with Curcumin Loaded S1

Figure 4: Curcumin loaded Patch

Figure 5: Blank Patch
Thickness of the patch: The thickness of the patches is measured by a Vernier calliper.
Table 3: The average thickness of all the patches
|
No of Patches |
Patch formulations |
Thickness |
|
1 |
Blank Patch |
0.110 mm |
|
2 |
Pure drug loaded patch |
0.160 mm |
|
3 |
Base catalyzed silica loaded drug |
0.196 mm |
|
4 |
Acid catalyzed silica loaded drug |
0.190 mm |
Swelling Index of the patches:
Swelling Index is measured as the increase in the weight% of a patch (or any polymer-based film) due to its absorption of liquid (usually water or buffer) that gives the information about its ability to swell and retain fluid under specific conditions.[14]To measure the swelling index a strip of (1*1)cm2 was cut out from all the patches and weighed. Then, it was kept in a Petri dish and phosphate buffer solution (PBS) of pH 7.4 was added until it was completely immersed. Then in every 1 h, the strip was taken out, blotted to eliminate the excess water and weighed again. This process was continued for up to 6 hrs, and the following formula used to calculate the value of the swelling index at different time interval.
Swelling index = ((W0 –Wt. )/W0 )*100
Where: W0 = Initial weight of the dry patch
Wt. = Weight of the patch after swelling (at time t)

Figure 6: Swelling index % of three types of patches
CHARECTERIZATIONS:
For the characterization of the nanoparticles, BET)(Micro Meritics, Model no.: Gemini VII), XRD(Rigaku, Ultima IV, Japan), FTIR(Prestige 22,Shimadzu) and DLS-ZETA Potential (Zetasizer ZEM. 3600 Instrument) analysis were performed. BET (Brunauer–Emmett–Teller) analysis was used to measure the surface area and pore volume of the silica and silica entrapped curcumin nanoparticles’-ray Diffraction (XRD)analysis helped to confirm the crystalline or amorphous nature of the material. FTIR (Fourier Transform Infrared Spectroscopy) was used to identify chemical bonds and functional group present. Dynamic Light Scattering (DLS) provided data on the average particle size distribution and zeta potential gives information about the surface charge distribution of the nanoparticles. These techniques validated the successful synthesis of silica nanoparticles and encapsulation of curcumin within it.
XRD Analysis:
The absence of sharp and intense diffraction peaks for the silica nanoparticles (both S1 & S2) confirmed their predominantly amorphous nature, as expected from the sol-gel synthesis process. The absence of well-defined peaks in curcumin also indicates its amorphous nature and we can conclude that curcumin lacks long-range crystalline order. When curcumin was incorporated into silica nanoparticles (both S1 & S2) the XRD pattern of the drug-loaded silica nanoparticles also displayed an amorphous profile, with no emergence of sharp peaks ,again confirming that curcumin remained in an amorphous or molecularly dispersed state within the silica matrix. This amorphous form is beneficial for transdermal drug delivery, as it typically results in enhanced solubility and improved release characteristics compared to the crystalline form. Characteristics compared to the crystalline form.

(a)XRD image of bare curcumin, acid cat silica (S2) and curcumin loaded S2

(b)XRD image of bare curcumin, base cat silica(S1) and curcumin loaded S1.
Figure 7: XRD patterns.
FTIR Analysis:
FTIR spectra of the pure drug ,silica nanoparticles and drug loaded silica nanoparticles were taken within the range of 400–4000 cm−1.The FTIR spectrum of the curcumin-loaded silica matrix confirms the successful incorporation of curcumin within the silica framework. The characteristic broad band observed around 3200–3600 cm−1 that corresponds to the O–H stretching vibrations. It indicates the presence of hydroxyl groups from both silica and curcumin. A peak near 1600-1700 cm−1 is attributed to the C=O and C=C stretching vibrations of curcumin, confirming the presence of conjugated diketone structure. Additional peaks observed at around 1200–1300 cm−1 correspond to -C–O stretching vibrations, indicative of methoxy groups in curcumin. The presence of peaks around 900-1000cm−1 is assigned to Si–O–Si asymmetric stretching, a typical feature of the silica network.[15][16]
The presence of characteristic curcumin peaks in the FTIR spectrum indicates that curcumin retains its chemical structure after incorporation and the overlapping spectral features confirm its successful encapsulation within the silica matrix.
FTIR Analysis of transdermal patch:
Fourier Transform Infrared Spectroscopy (FTIR)plays a vital role in confirming the successful entrapment of drugs, drug loaded nanoparticles within the patch and also in verifying the formation of transdermal patches’ spectra of the pure polymers and transdermal patches were taken within the range of 400–4000 cm−1.The FTIR spectrum of the different transdermal patches formulated using ethyl cellulose (EC), polyvinylpyrrolidone (PVP) and polyvinyl alcohol (PVA) displays characteristic peaks corresponding to both the polymer matrix and the encapsulated curcumin.
In the FTIR spectra of all the transdermal patches, significant peaks of are observed within the range of 700-1500 cm−1 as shown in the figure. The spectra of pure curcumin transdermal patches showed principal peaks of the drug in the range of 800-1600 cm−1.The major peaks of curcumin in S1 & S2 in its transdermal formulation were observed between the same range as earlier and peak at 2800-3000 cm−1, as portrayed by the dotted circle. Moreover, the patches containing nanomedicines proved the presence of SNPs by showing a broad strong band around 1400-1500cm−1 and 1800 for the stretching of the ether group and C=O bond, a peak near 3000 cm−1 reflects the O-H stretching, present in TEOS. However, few additional peaks were observed in all patches due to the presence of other constituting polymers.[15][17]
In addition, a peak near 400-600 cm−1 corresponds to C–O stretching of PVA and EC, indicating the integrity of the polymer matrix. The presence of these characteristic peaks of curcumin along with polymeric peaks indicates successful incorporation of curcumin into the patch without any significant chemical interaction or degradation.

(a)FTIR image of bare curcumin, acid cat silica(S1) and curcumin loaded S2.

(b)FTIR image of bare curcumin, base cat silica(S2) and curcumin loaded S1.

(c)FTIR image of different polymers and transdermal patch formulations (F1, F2, F3)
Figure 8: FTIR plots.
BET Analysis:
Nitrogen multilayer adsorption measured as a function of relative pressure (BET method) evaluated the surface area of the nanoparticles. BJH analysis was also employed to determine the average pore diameter and pore volume. The surface area for S1 and S2 formulations were 802.1262 cm2/gm and 979.9490 cm2/gm, respectively; the pore diameters for those formulations were 4.1840 nm and 3.0938 nm, respectively; also, the pore volumes were 0.722741 cm3/gm and 0.655032 cm3/gm respectively. After drug encapsulation, the surface area and pore volume decreased, whereas a small but negligible decrease in pore diameter was also observed for both.
Table 4: BET data of bare silica and curcumin loaded silica
|
Sample type |
Surface area (m2 )/gm |
Pore diameter (nm) |
Pore volume (cm3/gm) |
|
Base-catalyzed SNPs(S1) |
802.1262 |
4.1840 |
0.722741 |
|
Curcumin -loaded S1 |
610.2930 |
3.7457 |
0.508965 |
|
Acid-catalyzed SNPs(S2) |
979.9490 |
3.0938 |
0.655032 |
|
Curcumin loaded S2 |
689.9974 |
2.3932 |
0.168330 |
DLS-ZETA POTENTIAL Analysis:
Dynamic Light Scattering (DLS) analysis was conducted to evaluate the hydrodynamic size and particle size distribution of the S1 and S2 formulations. The DLS measurements revealed a single, sharp peak for each sample which indicates a monodisperse particle distribution with uniform size distribution and minimal aggregation. The mean hydrodynamic diameter was approximately 197.6 nm for S1 and 267.2 nm for S2.The relatively small and consistent size distributions suggest good colloidal stability and homogeneity of the nanoparticle suspensions, which is advantageous for curcumin encapsulation.
The zeta potential of the synthesized silica nanoparticles was found to be –21.76 mV for S1 and -17.12 mV for S2, indicating good colloidal stability due to sufficient electrostatic repulsion between particles. The negative surface charge is attributed to the presence of silanol (Si–OH) groups on the silica surface, which deprotonate in aqueous medium. This stable dispersion is favourable for further drug loading and biomedical applications.

Figure 9: Particle size distribution curve of acid-catalysed SNPs (S2) and base-catalysed SNPs(S1)

(a) Zeta potential distribution curve of acid catalysed silica nanoparticles

(b) Zeta potential distribution curve of base catalysed silica nanoparticles.
Figure 10: DLS-ZETA Potential distribution.
ANTIBACTERIAL PROPERTY STUDY:
Bacteria strain preparation:
Gram positive bacteria Staphylococcus aureus(S.aureus) and Gram-negative bacteria Pseudomonas aeruginosa(P.aeruginosa) bacterial strains are prepared in nutrient broth medium at 37 degree Celsius in BOD shaker at 120 rpm with proper agitation.[18]
MIC Study:
MIC or the minimum inhibitory concentration tells that much concentration of any drug can inhibit the growth of any tested micro-organism. To determine the MIC study was performed by using the broth microdilution method. Using the standard broth dilution method, the MIC assay is carried out in a 96-well plate. This assay is done at room temperature. [18][19]
Zone of inhibition study:
Solid agar plates containing nutrient agar (NA) were prepared and inoculated with 200µl of Staphylococcus aureus and Pseudomonas aeruginosa cultures grown in nutrient broth (NB).Antibacterial activity of curcumin and curcumin entrapped silica nanoparticles were evaluated using the disc diffusion method. Sterile discs impregnated with the formulations were placed onto the agar surface and the plates were incubated. The presence of clear zones around the discs indicates its ability to inhibit bacterial growth with the diameter of the zones reflecting the relative potency.[18]
Table 5: MIC values of the two bacteria strains.
|
Bacteria Strain |
MIC values (mg/ml) |
|
Staphylococcus aureus (S.aureus) Pseudomonas aeruginosa (P.aeruginosa) |
250 mg/ml
500 mg/ml |
Zone of inhibition analysis:
From the result of the disc diffusion test we can conclude the followings:
So, water and silica disc without any zones confirms that silica does not have any antibacterial effect.
The zone of inhibition from silica encapsulated curcumin disc also confirms that the drug is loaded into the silica nanoparticles.
Figure 11: Zone of inhibition study of gram positive and gram-negative bacteria.

Figure 12: Effect of curcumin on bacterial growth kinetics of Pseudomonas aeruginosa and Staphylococcus aureus.
Bacteria growth kinetics study:
Bacterial growth kinetics study was performed to evaluate the antibacterial efficacy of curcumin against Staphylococcus aureus and Pseudomonas aeruginosa. The bacterial cultures are incubated in nutrient broth for 24 hours at 37°C with constant shaking and 2ml of each sample is withdrawn at a regular interval of 1hour.Optical density (OD) measured at 627 nm are recorded to monitor the growth patterns.[18]. The growth curves reveal a concentration-dependent inhibition of bacterial proliferation, with curcumin significantly delaying the log phase and reducing the overall growth rate of both strains. S.aureus, a Gram-positive bacterium that exhibits greater sensitivity to curcumin compared to P.aeruginosa, a Gram-negative strain. These results suggest that curcumin disrupts bacterial growth by interfering with cellular processes that highlights its potential as an antibacterial agent.[18] All these findings suggest that curcumin possess promising antimicrobial properties.
RELEASE KINETICS STUDY:
I had taken 500 mg of curcumin-loaded Silica nanoparticles (both S1 and S2 types separately)and it was exposed to sodium acetate buffer of pH 5.5 and phosphate buffer (PBS) of pH 7.4 in a BOD shaker at 110 rpm for 168 hours. All of the dissolutions were carried out in 50 mL of dissolution media and 2ml of sample solution was withdrawn at various time intervals and an equal volume of dissolution media was added to keep the total volume equal. The samples were then analysed by UV-Visible spectrophotometer. The plot of percentage cumulative release against time is drawn.
The prepared patches with a dimension of (1 × 1)cm2 were located individually on the stratum corneum side of the human skin that was soaked overnight in the phosphate buffer solution (PBS) of pH 7.4. Then, the skin with the piece of patch is placed into Franz diffusion cell in such a way so that the dermis side of the skin remains towards the receptor part of the cell containing 100 mL of PBS at room temperature. The solution in the receptor compartment was then continuously stirred using a magnetic bead on a magnetic stirrer at rpm of 50. Now 2ml of the solution is collected from the receptor part of the Franz diffusion cell at different time intervals (up to 144hrs)and at the same time an equal volume of PBS is added to keep the total volume same. Finally, the samples were analysed under a UV-Visible spectrophotometer to determine the curcumin concentration permeated through the skin during this total time.
The data obtained from the above studies are plotted in various kinetic models such as zero order, first order, Higuchi model and Korsmeyer-Peppas model. Zero-order describes that the rate of drug release is not subjected to the change in initial drug concentration, so it encourages slow release from the matrix. That we can see from the Zero order equation i.e. C=k0t,where k0 is rate constant. Whereas, first-order model portrays that the rate of drug release is directly proportional to the remaining drug concentration in the matrix i.e. log C= log C0 - k1t/2.303,where C0=Initial concentration of drug ,k1=first order rate constant. Moreover, Higuchi model explains the diffusion-controlled release of the drug from the encapsulated matrix based on the Fick’s law which can be expressed as Q=kt1/2,where Q=Cumulative amount of drug released & k= Higuchi constant. Lastly the Korsmeyer Peppas model mathematically expressed as Mt/M∞ = Ktn; where Mt/M∞ = fraction of drug released in time t, K= rate constant; the “n” values are called the “release exponent” and the value of n ≤ 0.45 indicates Fickian diffusion, 0.45 <n < 0.89 non-Fickian (anomalous) diffusion, n = 0.89 non-Fickian (case II transport) and n >0.89 non-Fickian (super case II transport).[20][21][22]

(a)Cumulative release of curcumin from silica matrix at two different pH medium.

(b)Cumulative release of curcumin from different patch formulations
Figure 13: Cumulative release of curcumin.
Table 6: Kinetic data of curcumin release for the first 5 hours obtained from different silica matrix (S1&S2) in two different pH mediums
|
pH |
Sample |
Zero order (R2) |
First order (R2) |
Higuchi model (R2) |
Koresmeyer peppas (R2) |
n value |
Release mechanism |
|
5.5 |
S1 |
0.9114 |
0.9879 |
0.9941 |
0.9887 |
0.7845 |
Non-Fickian transport |
|
5.5 |
S2 |
0.8164 |
0.8511 |
0.911 |
0.794 |
0.5191 |
Non-Fickian transport |
|
7.4 |
S1 |
0.9548 |
0.9663 |
0.995 |
0.6889 |
0.4425 |
Fickian transport |
|
7.4 |
S2 |
0.8049 |
0.828 |
0.8983 |
0.778 |
0.61 |
Non-Fickian transport |
Table 7: Kinetic data of curcumin release for 24-144hours obtained from different silica matrix (S1 & S2) in two different pH mediums
|
pH |
Sample |
Zero order (R2) |
First order (R2) |
Higuchi model (R2) |
Koresmeyer peppas (R2) |
n value |
Release mechanism |
|
5.5 |
S1 |
0.9771 |
0.9665 |
0.9642 |
0.974 |
0.3362 |
Fickian transport |
|
5.5 |
S2 |
0.9182 |
0.917 |
0.9303 |
0.9381 |
0.5401 |
Non-Fickian transport |
|
7.4 |
S1 |
0.7506 |
0.818 |
0.8182 |
0.8261 |
0.5686 |
Non-Fickian transport |
|
7.4 |
S2 |
0.8826 |
0.9213 |
0.9386 |
0.9672 |
0.144 |
Fickian transport |
Table 8: Kinetic data of curcumin release for the first 5 hours from different patch formulations.
|
Patch formulation |
Zero order (R2) |
First order (R2) |
Higuchi model (R2) |
Koresmeyer peppas (R2) |
n value |
Release mechanism |
|
F1 |
0.9819 |
0.9889 |
0.9921 |
0.9827 |
0.7902 |
Non-Fickian transport |
|
F2 |
0.9654 |
0.9787 |
0.9919 |
0.9837 |
0.4609 |
Non-Fickian transport |
|
F3 |
0.9874 |
0.9846 |
0.9511 |
0.817 |
1.6748 |
Super case II transport |
Table 9: Kinetic data of curcumin release for 24-144 hours from different patch formulations.
|
Patch formulation |
Zero order (R2) |
First order (R2) |
Higuchi model (R2) |
Koresmeyer peppas (R2) |
n value |
Release mechanism |
|
F1 |
0.975 |
0.9777 |
0.9784 |
0.9741 |
0.4097 |
Fickian diffusion |
|
F2 |
0.9006 |
0.9061 |
0.9157 |
0.8817 |
0.3117 |
Fickian diffusion |
|
F3 |
0.9074 |
0.9229 |
0.9674 |
0.9665 |
0.374 |
Fickian diffusion |
Table 10: Cumulative release of curcumin in SSF and SBF from S1 and S2 matrices.
|
Set |
pH media |
Sample name |
Cumulative release (max) |
|
1 |
5.5 |
S1 |
67% |
|
2 |
5.5 |
S2 |
64% |
|
3 |
7.4 |
S1 |
73% |
|
4 |
7.4 |
S2 |
69% |
Table 11: Cumulative release of curcumin from different patch formulations.
|
Set |
Patch formulations |
Cumulative release % |
|
1 |
F1 |
59% |
|
2 |
F2 |
67% |
|
3 |
F3 |
79% |

(a)Best fitted models of in vitro drug release from S1 & S2 at 7.4 medium.

(b)Best fitted models of in vitro drug release from S1 & S2 at 5.5 medium.

(c)Best fitted models of ex-vivo drug release from F1,F2, F3 patch formulations.
Figure 14: Best fitted release kinetic model plots.
RESULTS AND DISCUSSIONS:
Curcumin is successfully encapsulated into silica nanoparticles synthesized in both acid and base catalysis medium via sol gel route with molar ratio 1:2:1 (TEOS: ethanol: water) is explored. Characterization studies have confirmed the successful formation of mesoporous silica. Firstly, XRD analysis has revealed distinct structural features of the samples. Pure silica and curcumin both showed broad hump, characteristic of an amorphous structure due to the lack of long-range molecular order. Upon encapsulation within the silica matrix, the resulting silica-curcumin again displayed an amorphous nature. BET analysis indicates that acid-catalysed silica has a higher surface area and shows smaller pore diameters, potentially restricting curcumin diffusion. Decrease in the pore diameter of both S1 and S2 formulations after drug loading implies that drug molecules are entrapped into the pores.S1 had a relatively lower surface area with pore size enlargement by the dissolution- precipitation process or generally called Ostwald ripening of silica particles in a basic medium. The acid catalyst favoured hydrolysis reaction, which mainly leads to the formation of the long polymeric chain. This phenomenon could explain the lowering of surface area in the case of S1.From DLS Zeta the particle size was achieved 197.6 nm and 267.2 nm hence the SNPs might be able to cross the skin barrier efficiently, especially through hair follicles and sweat glands with encapsulated curcumin. FTIR analysis confirmed the successful encapsulation of curcumin within the silica matrix, as indicated by the characteristic peaks of both silica (Si–O–Si) and curcumin (C=C aromatic). In the transdermal patches, the presence of key functional groups from PVA, PVP, and EC along with curcumin-loaded silica peaks indicated compatibility and successful incorporation without chemical degradation.
Minimum inhibitory concentration of curcumin was performed against gram positive and gram-negative bacteria. Then in the disc diffusion assay for antibacterial activity against these two bacteria pure curcumin exhibited the zone of inhibition due to fast diffusion through the agar medium. Silica-loaded curcumin formulation displayed smaller inhibition zones compared to curcumin and it indicates the successful encapsulation of curcumin into silica matrix and also the bacterial growth kinetics study clearly demonstrated the inhibitory effect of curcumin on the selected bacterial strains at the MIC concentration. All the results support its potential as a natural antimicrobial agent, especially for sustained-release systems where prolonged bacterial inhibition is desired.
The in vitro drug release profile of curcumin-loaded silica nanoparticle formulations exhibited a biphasic release pattern including an initial burst release followed by a sustained release phase that slowed down over time, around after 72-96 hours. Based on the regression coefficient (R2) values, the Higuchi model is found to be the best-fitted model for the burst release of curcumin from both S1 and S2 formulations in pH 5.5 and7.4 media. In pH 5.5, S1 formulation showed a release exponent (n) value of 0.7845, indicating a non-Fickian diffusion mechanism, while S2 has n value of 0.5191, also suggesting non-Fickian transport. In pH 7.4, S1 followed the Higuchi model with n value of 0.4425, corresponding to Fickian diffusion, whereas S2 exhibited n value of 0.610, indicating a non-Fickian transport mechanism. Later (24–144 hrs),the drug release follows the Kores Meyer Peppas model(S1& S2) with n values 0.3362 & 0.5401 in 5.5 pH medium and with n value 0.5686 & 0.144 in 7.4 pH medium. So, during 24-144 hours, the drug release from S1&S2 in both the mediums followed the Kores Meyer Peppas model and also Fickian and non Fickian diffusion mechanism. These results suggest that the release behaviour of curcumin is influenced by both the formulation and the pH of the release medium’s vitro drug release study showed that poorly aqueous soluble drug curcumin can be dissolved to an extent using a nanocarrier silica. From the release profile it is revealed that the release was very fast initially and after that the sustained release was observed in the second phase which is gradually slowed down after 72hrs.The release percentages in skin pH (pH 5.5) from S1 and S2 were about 67% and 64% respectively, whereas in physiological pH (pH 7.4) 73% and 69%respectively.
In the case of curcumin loaded patches, lower moisture content contributed to improved stability of the formulations. The incorporation of silica nanoparticles those are inherently hydrophilic due to the presence of Si–O bonds are capable of forming hydrogen bonds with water molecules that increase the hydrophilicity of the matrix. This enhanced surface wettability and promoted water penetration caused higher swelling index in the F1 and F2 formulations.
For the ex vivo release from the transdermal patch again from the regression coefficient (R2) value we can evaluate the most appropriate kinetic model. During the initial release phase (for the first 5 hours),F1 & F2 formulations exhibits Higuchi model with n values 0.7902 & 0.4609 respectively and F3 exhibits First order kinetic model with n value 1.6748. Later (24–144 hrs),the drug release again follows the Higuchi model(F1& F2) with n values 0.4097 & 0.3117 and Kores Meyer Peppas model(F3) with n value 0.374.So during 24-144 hours, the release from F1,F2& F3 followed the Higuchi model and Kores Meyer Peppas model and also Fickian diffusion mechanism. It suggests that the release process is diffusion-controlled and the curcumin molecules diffused through the silica matrix. The release mechanism is super case II transport during burst release period for F3,implying the drug release is ruled by a relaxation of the polymeric chain.[23]The non-Fickian release mechanism during the burst release period for F1 & F2 indicates the disentanglement of polymer in which the magnitude of polymer relaxation and velocity of solvent diffusion are similar.[24]The Fickian diffusion mechanism during sustained release period for F1,F2& F3 indicates the molecular diffusion is driven by chemical potential gradient.[7][25]
Although the F3 patch (plain curcumin) shows higher cumulative drug release we will go for the F1 patch formulation due to its sustained release. Curcumin has limited skin penetration efficiency so formulating it in silica and then incorporating it into transdermal patches significantly enhances it therapeutic activity. In F1, the silica matrix protects curcumin from degradation and allows gradual diffusion through hair follicles, sweat glands and also helps it to go into deeper epidermal layers, hence improving its retention and therapeutic efficiency. Thus, F1 offers a more stable and effective transdermal delivery system.
CONCLUSION:
Silica nanoparticles (SNPs) were successfully synthesized and curcumin was successfully encapsulated in them then these curcumin-loaded nanoparticles were effectively incorporated into a transdermal patch matrix. Preliminary qualitative evaluations were performed that supported the stable integration of the nanocarriers within the patch system. The results suggest that curcumin loaded silica nanoparticle based transdermal patches can serve as a promising therapeutic agent for sustained antibacterial action particularly for skin-related infections. The drug release kinetics revealed that the formulations are suitable for sustained and prolonged curcumin delivery. We can see that only curcumin loaded transdermal patch has demonstrated a higher cumulative drug release on human skin compared to acid and base-catalysed silica encapsulated formulations. But curcumin has low skin penetration efficiency due to its poor solubility and chemical instability. Initial burst release observed in the plain curcumin patch may result in rapid drug depletion reducing dermal retention. In contrast, the silica-based systems enable entrapment of curcumin within its porous nanostructure and facilitates diffusion-controlled sustained release which is the target in our study.
Moreover, silica nanoparticles protect curcumin from photodegradation while their nanoscale dimensions Favor transfollicular and trans appendageal transport. Therefore, despite lower overall cumulative release, silica-entrapped curcumin patches are more effective in achieving sustained, stable, and therapeutically relevant drug delivery.
ACKNOWLEDGEMENTS:
We are thankful to Dr Debasmita Chatterjee, Assistant Professor, Heritage Institute of Technology, Kolkata, India and all the lab members of School of materials science and nanotechnology, Jadavpur University, Kolkata, India, for their immense contribution to our research work. We are also thankful to IACS (Indian Association for the Cultivation of Science) and IISER Kolkata for providing us access to their Central Characterization Facilities for DLS-Zeta Potential and BET analysis, respectively.
REFERENCES





Ansua Roy, Saswati Saha, Satadal Das, Sourav Adhikary, Mahua Ghosh Chaudhuri, Silica Encapsulated Curcumin: A Transdermal Patch for Enhanced Sustained Drug Release Along with Its Antibacterial Activity, Int. J. of Pharm. Sci., 2025, Vol 3, Issue 8, 1078-1097. https://doi.org/10.5281/zenodo.16795628
 10.5281/zenodo.16795628
10.5281/zenodo.16795628